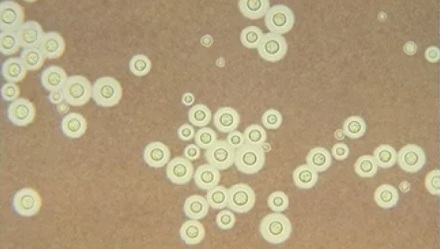

为什么有的人喂完鸽子就死了?
准确地说,这些人是接触了鸽子的便便。

鸽子便便里携带一种新型隐球菌,主要通过呼吸道来传播,感染后可能会导致隐球菌脑膜炎,分分钟要人命。
除了脑膜炎,新型隐球菌还会导致肺部感染,游荡到皮肤上,又会造成皮肤感染。

鸽子自己倒不会被感染,因为它的体温在 41~43℃,高于新型隐球菌的最佳生长温度 (37°C)。
总之,路边的鸽子,你不要摸。
准确地说,这些人是接触了鸽子的便便。
鸽子便便里携带一种新型隐球菌,主要通过呼吸道来传播,感染后可能会导致隐球菌脑膜炎,分分钟要人命。
除了脑膜炎,新型隐球菌还会导致肺部感染,游荡到皮肤上,又会造成皮肤感染。
鸽子自己倒不会被感染,因为它的体温在 41~43℃,高于新型隐球菌的最佳生长温度 (37°C)。
总之,路边的鸽子,你不要摸。